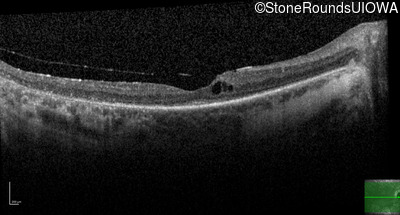
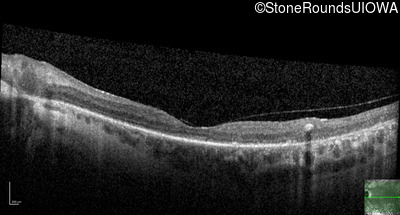
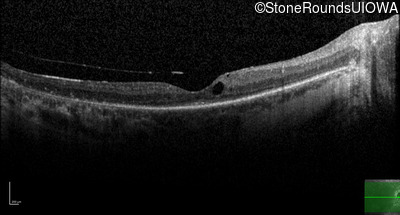

Case
SR1902
Student Mode
Type 2 Usher Syndrome (IB1b)
Female
Female
Hidden
SR1902
Student Mode
Type 2 Usher Syndrome (IB1b)
Female
Female
History
This 53 year old woman first noticed night blindness at age 18. More recently she has experienced constriction of her visual fields. She has worn hearing aids since childhood.
| Age at visit: 53 years |
Diagnosis & molecular findings
| Disease | Gene | Allele 1 variant(s) | Allele 2 variant(s) | Inheritance mode |
|---|---|---|---|---|
| Type 2 Usher Syndrome | ADGRV1 | Arg211 del2ggcAG | IVS66-2 A>T | AR |
Disease:
Gene:
Allele 1:
Arg211 del2ggcAG
Allele 2:
IVS66-2 A>T
Inheritance:
AR